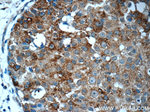
MAPKAPK2 Antibody in Immunohistochemistry (Paraffin) (IHC (P))
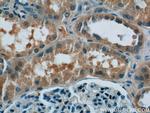
MAPKAPK2 Antibody in Immunohistochemistry (Paraffin) (IHC (P))
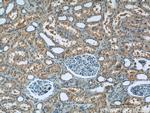
MAPKAPK2 Antibody in Immunohistochemistry (Paraffin) (IHC (P))

Search
Proteintech
MAPKAPK2 Polyclonal Antibody
{{$productOrderCtrl.translations['antibody.pdp.commerceCard.promotion.promotions']}}
{{$productOrderCtrl.translations['antibody.pdp.commerceCard.promotion.viewpromo']}}
{{$productOrderCtrl.translations['antibody.pdp.commerceCard.promotion.promocode']}}: {{promo.promoCode}} {{promo.promoTitle}} {{promo.promoDescription}}. {{$productOrderCtrl.translations['antibody.pdp.commerceCard.promotion.learnmore']}}
产品信息
13949-1-AP
种属反应
已发表种属
宿主/亚型
分类
类型
抗原
偶联物
形式
浓度
规格
纯化类型
保存液
内含物
保存条件
运输条件
产品详细信息
Immunogen sequence: MLSNSQGQS PPVPFPAPAP PPQPPTPALP HPPAQPPPPP PQQFPQFHVK SGLQIKKNAI IDDYKVTSQV LGLGINGKVL QIFNKRTQEK FALKMLQDCP KARREVELHW RASQCPHIVR IVDVYENLYA GRKCLLIVME CLDGGELFSR IQDRGDQAFT EREASEIMKS IGEAIQYLHS INIAHRDVKP ENLLYTSKRP NAILKLTDFG FAKETTSHNS LTTPCYTPYY VAPEVLGPEK YDKSCDMWSL GVIMYILLCG YPPFYSNHGL AISPGMKTRI RMGQYEFPNP EWSEVSEEVK MLIRNLLKTE PTQRMTITEF MNHPWIMQST KVPQTPLHTS RVLKEDKERW EDVKEEMTSA LATMRVDYEQ IKIKKIEDAS NPLLLKRRKK ARALEAAALA H (1-400 aa encoded by BC036060)
靶标信息
MAPKAPK2 mediates p38 and ERK signaling in vivo. It is known to be involved in many cellular processes including stress and inflammatory responses, nuclear export, gene expression regulation, and cell proliferation. MAPKAPK2 encodes a member of the Ser/Thr protein kinase family. MAPKAPK2 is regulated through direct phosphorylation by p38 MAP kinase. In conjunction with p38 MAP kinase, MAPKAPK2 is known to be involved in many cellular processes including stress and inflammatory responses, nuclear export, gene expression regulation and cell proliferation. Heat shock protein HSP27 was shown to be one of the substrates of this kinase in vivo. Two transcript variants encoding two different isoforms have been found for MAPKAPK2.
仅用于科研。不用于诊断过程。未经明确授权不得转售。
生物信息学
蛋白别名: MAP kinase-activated protein kinase 2; MAPK-activated protein kinase 2; MAPKAP kinase 2; MAPKAPK-2; mitogen-activated protein kinase-activated protein kinase 2
基因别名: AA960234; MAPKAP-K2; MAPKAPK2; MK-2; MK2; Rps6kc1
UniProt ID: (Human) P49137, (Mouse) P49138
Entrez Gene ID: (Human) 9261, (Mouse) 17164